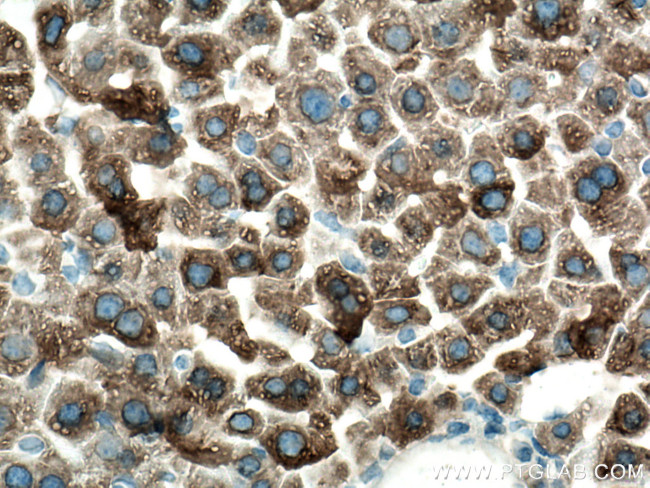
CYP3A4 Antibody in Immunohistochemistry (Paraffin) (IHC (P))

Search
Proteintech
CYP3A4 Monoclonal Antibody (2F11C4)
{{$productOrderCtrl.translations['antibody.pdp.commerceCard.promotion.promotions']}}
{{$productOrderCtrl.translations['antibody.pdp.commerceCard.promotion.viewpromo']}}
{{$productOrderCtrl.translations['antibody.pdp.commerceCard.promotion.promocode']}}: {{promo.promoCode}} {{promo.promoTitle}} {{promo.promoDescription}}. {{$productOrderCtrl.translations['antibody.pdp.commerceCard.promotion.learnmore']}}
产品信息
67110-1-IG
种属反应
宿主/亚型
分类
类型
克隆号
抗原
偶联物
形式
浓度
规格
纯化类型
保存液
内含物
保存条件
运输条件
产品详细信息
Aliquoting is unnecessary for -20°C storage.
靶标信息
This gene encodes a member of the cytochrome P450 superfamily of enzymes. The cytochrome P450 proteins are monooxygenases that catalyze many reactions involved in drug metabolism and synthesis of cholesterol, steroids and other lipids. This protein localizes to the endoplasmic reticulum and its expression is induced by glucocorticoids and some pharmacological agents. This enzyme is involved in the metabolism of approximately half the drugs in use today, including acetaminophen, codeine, cyclosporin A, diazepam and erythromycin. The enzyme also metabolizes some steroids and carcinogens. This gene is part of a cluster of cytochrome P450 genes on chromosome 7q21.1. Previously another CYP3A gene, CYP3A3, was thought to exist; however, it is now thought that this sequence represents a transcript variant of CYP3A4. Alternatively spliced transcript variants encoding different isoforms have been identified.
仅用于科研。不用于诊断过程。未经明确授权不得转售。
生物信息学
蛋白别名: 1,4-cineole 2-exo-monooxygenase; 1,8-cineole 2-exo-monooxygenase; Albendazole monooxygenase (sulfoxide-forming); Albendazole sulfoxidase; catalyzes oxidative metabolism of xenobiotics; Cholesterol 25-hydroxylase; CYP; CYPIIIA3; CYPIIIA4; cytochrome P-450 nifedipine oxidase; Cytochrome P450 3A3; Cytochrome P450 3A4; Cytochrome P450 HLp; Cytochrome P450 NF-25; cytochrome P450, family 3, subfamily A, polypeptide 4; cytochrome P450, subfamily IIIA (niphedipine oxidase), polypeptide 3; cytochrome P450, subfamily IIIA (niphedipine oxidase), polypeptide 4; Cytochrome P450-PCN1; glucocorticoid-inducible cytochrome P-450; glucocorticoid-inducible P450; MGC126680; Nifedipine oxidase; P450; P450-III, steroid inducible; P450-PCN1; Quinine 3-monooxygenase; taurochenodeoxycholate 6-alpha-hydroxylase; unnamed protein product
基因别名: CP33; CP34; CYP3A; CYP3A3; CYP3A4; CYPIIIA3; CYPIIIA4; HLP; NF-25; P450C3; P450PCN1; VDDR3
UniProt ID: (Human) P08684
Entrez Gene ID: (Human) 1576